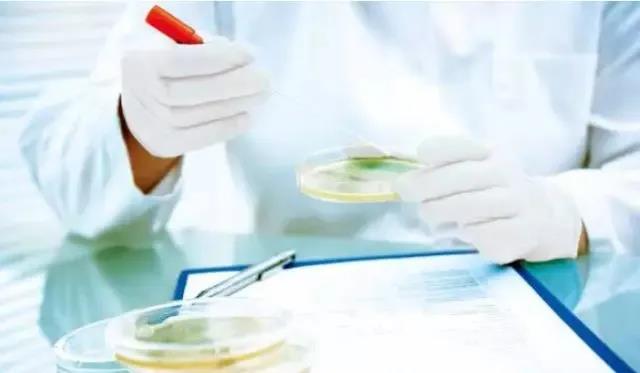

去年6月,溫州市市場監(jiān)督管理局發(fā)布夏令食品安全專項監(jiān)督抽檢通告。其中,“奧雪”牌雙黃蛋(咸蛋黃牛奶味)雪糕被檢出菌落總數(shù)和大腸菌群超標(biāo)。
除此之外,一些化妝品、辣條、甚至同學(xué)們喜歡吃的“達(dá)利園面包”等,都被查出過菌落總數(shù)超標(biāo)。。。(數(shù)據(jù)來源:央視網(wǎng))
這群我們?nèi)庋劭床灰姷男∩铮茖W(xué)家如何檢測的呢?
菌落指的是生長在固體培養(yǎng)基上,通常由一個細(xì)胞生長繁殖而成的肉眼可見的微生物細(xì)胞群體,菌落形成單位以CFU來計。
圖源:中國食品藥品監(jiān)管雜志
菌落總數(shù)是指食品檢樣經(jīng)過處理后,在一定條件下(如培養(yǎng)基成分、培養(yǎng)溫度和時間、pH、需氧性質(zhì)等)培養(yǎng)后,所得1mL(或1g)檢樣中形成的菌落總數(shù)。GB/T4789.2中規(guī)定的“一定時間”通常指48h~72h培養(yǎng)基中長出的菌落,這一時間段只有細(xì)菌能夠長成菌落,菌落總數(shù)即活的細(xì)菌數(shù),且不包括嗜冷菌、嗜熱菌、厭氧菌等特殊環(huán)境條件下生長的菌。但菌落總數(shù)并不能區(qū)分細(xì)菌的種類,有時被稱為雜菌數(shù)或需氧菌數(shù)等。

注:G+菌為革蘭氏陽性菌,細(xì)胞壁較厚;G-菌為革蘭氏陰性菌,細(xì)胞壁較薄
傳統(tǒng)檢測菌落總數(shù)的方法是,“平板活菌計數(shù)法”,具體操作流程如下:
1、檢樣稀釋及培養(yǎng)
(1)以無菌操作,將檢樣25g(或25mL)剪碎以后,放于含有225mL滅菌生理鹽水或其他稀釋液的滅菌玻璃瓶內(nèi)(瓶內(nèi)預(yù)先置適當(dāng)數(shù)量的玻璃珠)或滅菌乳缽內(nèi),經(jīng)充分振搖或研磨做成1:10的均勻稀釋液。
固體檢樣在加入稀釋液后,最好置滅菌均質(zhì)器中以8000~100000r/min的速度處理1min,做成1:10的均勻稀釋液。
(2)用1mL滅菌吸管吸取1:10稀釋液1mL,沿管壁徐徐注入含有9mL滅菌生理鹽水或其他稀釋的試管內(nèi)(注意吸管尖端不要觸及管內(nèi)稀釋液,下同),振搖試管混合均勻,做成1:100的稀釋液。
(3)另取1mL的滅菌吸管,按上項操作順序作10倍遞增稀釋液,如此每遞增稀釋一次,即換用1支1mL滅菌吸管。
(4)根據(jù)食品衛(wèi)生標(biāo)準(zhǔn)要求或?qū)z樣污染情況的估計,選擇2~3個適宜稀釋度,分別在作10倍遞增稀釋的同時,即以吸取該稀釋度的吸管移1mL稀釋液于滅菌平皿內(nèi),每個稀釋度作兩個平皿。
(5)稀釋液移入平皿后,應(yīng)及時將涼至460C營養(yǎng)瓊脂培養(yǎng)基[可放置在((46±1)℃)水浴鍋內(nèi)保溫]注入平皿15mL~20mL,并轉(zhuǎn)動平皿使混合均勻,同時將營養(yǎng)瓊脂培養(yǎng)基傾入加有1mL稀釋液(不含樣品)的滅菌平皿內(nèi)作空白對照。
(6)等瓊脂凝固后,翻轉(zhuǎn)平板,置(36±1)℃恒溫箱內(nèi)培養(yǎng)(48±2)h取出,計算平板內(nèi)菌落數(shù)目乘以倍數(shù),即得1g(1mL)樣品所含菌落總數(shù)。

一是用于監(jiān)督食品的清潔狀態(tài),反映食品在生產(chǎn)過程中是否符合衛(wèi)生要求。食品中細(xì)菌數(shù)量越多,說明食品被污染的程度越重、越不新鮮、對人體健康威脅越大。相反,食品中細(xì)菌數(shù)量越少,說明食品被污染的程度越輕,食品衛(wèi)生質(zhì)量越好。
二是預(yù)測食品存放的期限程度。食品中細(xì)菌數(shù)量越少,食品可存放的時間就越長,相反,食品的可存放時間就越短。但是目前在食品細(xì)菌數(shù)量和腐敗變質(zhì)之間還難以找出適用于任何情況的對應(yīng)關(guān)系。同時,用于判定食品腐敗變質(zhì)的界限數(shù)值出入也較大。
1、有益菌包括著名的雙歧桿菌、乳酸菌。對人體有損害的其實是致病菌(同樣著名的有:沙門氏菌、金黃色葡萄球菌、霍亂弧菌、痢疾桿菌),這些病菌才是引起腹瀉、腹痛、臟器損傷的元兇。所以,菌落總數(shù)超標(biāo)只意味著致病菌超標(biāo)的機(jī)會增大,危害人體健康的幾率增大。它一定程度能反映產(chǎn)品的衛(wèi)生狀況,同食品安全并不直接相關(guān)。菌落總數(shù)指標(biāo)只有和其他一些指標(biāo)配合起來,才能對食品衛(wèi)生質(zhì)量做出比較正確的判斷。
2、在食品安全國家標(biāo)準(zhǔn)中,不同的食品,菌落總數(shù)的要求都不一樣。
《食品安全國家標(biāo)準(zhǔn)熟肉制品》(GB 2726—2016)中規(guī)定熟肉制品(除發(fā)酵肉制品外),一個樣品的5次檢測結(jié)果均不得超過105CFU/g且至少3次檢測結(jié)果不超過104CFU/g。
《食品安全國家標(biāo)準(zhǔn) 糕點(diǎn)、面包》(GB 7099—2015)中規(guī)定,糕點(diǎn)中的菌落總數(shù)5次檢測結(jié)果均不超過105CFU/g且至少3次檢測結(jié)果不超過104CFU/g。
《食品安全國家標(biāo)準(zhǔn)蜜餞》(GB 14884—2016)中規(guī)定,單個蜜餞樣品的5次檢測結(jié)果均不得超過104CFU/g且至少3次檢測結(jié)果不超過103CFU/g。
《食品安全國家標(biāo)準(zhǔn)沖調(diào)谷物制品》(GB 19640—2016)中規(guī)定,同批次5個獨(dú)立包裝產(chǎn)品中菌落總數(shù)的檢測結(jié)果不允許有超過105CFU/g的,且至少3個包裝產(chǎn)品檢測結(jié)果不超過104CFU/g。

《食品安全國家標(biāo)準(zhǔn)蜂蜜》(GB 14963-2011)

《食品安全國家標(biāo)準(zhǔn)冷凍飲品和制作料》(GB 2579-2015)
3、當(dāng)然有些食品本身含有數(shù)值較高的正常菌群,如新鮮的水果和蔬菜、含新鮮水果和蔬菜的即食食品(包括蔬菜沙拉、現(xiàn)制現(xiàn)售的果蔬汁飲料)、發(fā)酵食品(腐乳)和含發(fā)酵食品成分的即食食品,這些食品是不適宜使用菌落總數(shù)指標(biāo)來評價其衛(wèi)生質(zhì)量的,而需要關(guān)注的是致病微生物指標(biāo)。
值得一提的是,如果食品菌落總數(shù)超標(biāo),說明其產(chǎn)品的衛(wèi)生程度達(dá)不到基本的衛(wèi)生要求。那么在食品生產(chǎn)中,菌落總數(shù)超標(biāo)的原因有哪些呢?
1、生產(chǎn)環(huán)節(jié)
可能是個別企業(yè)所使用的原輔料初始菌數(shù)較高,又未按要求嚴(yán)格控制生產(chǎn)加工過程的衛(wèi)生條件,或者包裝容器清洗消毒不到位,生產(chǎn)加工環(huán)節(jié)原輔料、人員、設(shè)備、環(huán)境受到污染和消毒不徹底導(dǎo)致,將細(xì)菌帶入食品中,導(dǎo)致菌落總數(shù)超標(biāo)。
2、冷卻包裝環(huán)節(jié)
在冷卻、內(nèi)包裝過程中,遭受空氣中細(xì)菌二次污染,從而導(dǎo)致食品菌落總數(shù)含量超標(biāo)。
3、運(yùn)輸儲存環(huán)節(jié)
◇不吃生肉或未經(jīng)加熱煮熟的肉;由于大多數(shù)細(xì)菌是不耐熱的,如沙門氏菌,大腸桿菌等,因此把食物做熟再吃非常必要。
◇在準(zhǔn)備食物或就餐前洗凈雙手。
◇每接觸一種食物后,務(wù)必將砧板仔細(xì)洗凈,以免污染其它食物;切記生熟食品分開。
◇第四、購買商品時注意產(chǎn)品包裝是否有“生產(chǎn)許可證編號”;通過正規(guī)渠道購買。

當(dāng)前所在頁面:















